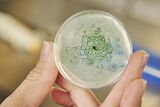
Cyanobakterien als Produzenten von Ethanol oder Wasserstoff – natürlicher Gentransfer könnte das möglich machen (Foto: Amadeus Bramsiepe, KIT)

| Nr. | Datum | Bild | Titel |
|---|---|---|---|
| 122 | 21.12.2020 | ![]() |
Oliver Kraft bleibt Vizepräsident für Forschung KIT-Senat bestätigt Wahl für zweite Amtszeit – Optimale Rahmenbedingungen für exzellente Forschung und für den wissenschaftlichen Nachwuchs zentrale Themen |
| 121 | 21.12.2020 | ![]() |
Thomas Hirth bleibt Vizepräsident für Innovation und Internationales KIT-Senat bestätigt Wahl für zweite Amtszeit – Schwerpunkte: Weiterentwicklung der Innovations- sowie Internationalisierungsstrategie, Stärkung des Wissenstransfers und Dialog mit der Gesellschaft |
| 120 | 17.12.2020 | ![]() |
Katalysatorforschung: Molekulare Sonden erfordern hochgenaue Rechnungen Forschende des KIT setzen fortgeschrittene Methoden mit Hybridfunktionalen zur Analyse der aktiven Zentren ein – Publikation in Physical Review Letters |
| 119 | 16.12.2020 | ![]() |
Weitere Schritte zur Vollendung der KIT-Fusion – Gesetz in Landtag eingebracht Theresia Bauer: „Bundesweit einmalige Rahmenbedingung für Forschung, Lehre und Innovation verstärken internationale Anziehungskraft“ - Holger Hanselka: „Gesetz zeigt Weg auf, wie wir am KIT die nächste Stufe der Einheit erklimmen können“ |
| 118 | 15.12.2020 | ![]() |
Nachhaltigkeit im Blick: Lithium aus dem Oberrheingraben für Batterien Forschungsprojekt nutzt Tiefengeothermie für die Gewinnung des Rohstoffs – gefördert vom Bundesministerium für Wirtschaft und Energie |
| 117 | 15.12.2020 | ![]() |
Dreidimensionaler Blick in aktive Katalysatoren Am KIT eingesetzte operando-Röntgenspektroskopie eröffnet neue Möglichkeiten für die Material- und Reaktionsdiagnostik – Forscher berichten in Nature Catalysis |
| 116 | 14.12.2020 | ![]() |
Frequenzdaten für stabile Stromversorgung Forschungsverbund untersucht Fluktuation in synchronen Netzgebieten – am KIT entwickelter Daten-Rekorder ermöglicht Datenaufzeichnung auf drei Kontinenten – Publikation in Nature Communications |
| 115 | 11.12.2020 | ![]() |
Kaum Sport – aber mehr Bewegung im Lockdown Während der Schließung von Schulen und Sportvereinen hat die Alltagsaktivität von Kindern und Jugendlichen zugenommen – Studie vergleicht Daten vor und während des Lockdowns im Frühjahr 2020 |
| 114 | 10.12.2020 | ![]() |
Signifikanter Effekt von Schulschließungen Datenanalyse zur Wirkung von Corona-Maßnahmen: Studie zur Effektivität nichtpharmazeutischer Interventionen im Kampf gegen die Pandemie |
| 113 | 10.12.2020 | ![]() |
KI: So bleibt der Mensch im Mittelpunkt KIT koordiniert Verbundprojekt MeKIDI zur Digitalisierung von Prozessen in der Energiewirtschaft |
| 112 | 09.12.2020 | ![]() |
Exzellente Forschung zu Bindungen der Actinoide und zu energieeffizienter Kommunikationstechnik Tonya Vitova und Laurent Schmalen vom KIT erhalten ERC Consolidator Grants für ihre Projekte |
| 111 | 09.12.2020 | ![]() |
Kompostierbare Displays für nachhaltige Elektronik Forschende des KIT entwickeln gedrucktes Display, das biologisch abbaubar ist – Veröffentlichung im Journal of Materials Chemistry |
| 110 | 08.12.2020 | ![]() |
KIT erhält Reallabor „Robotische Künstliche Intelligenz“ Künstliche Intelligenz durch humanoide Roboter erfahrbar machen: Bidirektionaler Austausch zwischen Gesellschaft und Forschung im Fokus |
| 109 | 08.12.2020 | ![]() |
Klimawandel verschlimmert Biodiversitätsschwund Studie in PNAS: Revidierte Ziele für biologische Vielfalt nach 2020 müssen Erderwärmung berücksichtigen |
| 108 | 03.12.2020 | ![]() |
Neue Produktionstechnologie für schwere Nutzfahrzeuge Brennstoffzellen ressourcenschonend, flexibel und kostengünstig herstellen – Baden-württembergisches Wirtschaftsministerium fördert mit rund einer Million Euro |
| 107 | 02.12.2020 | ![]() |
Energiewende: Dezentrale Energieversorgung durch innovative Strom-Wärme-Kopplung Praxistest für ein Redox-Flow-/Lithium-Ionen-Batteriepaar zur effizienten und ausdauernden Strom- und Wärmeversorgung |
| 106 | 01.12.2020 | ![]() |
Wie Katalysatoren effizienter arbeiten können DFG fördert neuen Sonderforschungsbereich „TrackAct“ zum Verständnis katalytischer Prozesse am KIT |
| 105 | 30.11.2020 | ![]() |
Onlinekurs Physik: Gut vorbereitet studieren Das MINT-Kolleg hat gemeinsam mit mehreren Hochschulen einen Brückenkurs Physik entwickelt – der TU9-zertifizierte Kurs ist ab sofort kostenlos im Internet verfügbar |
| 104 | 23.11.2020 | ![]() |
KIT und Audi arbeiten an Recycling-Methode für automobile Kunststoffe Geschlossener Kreislauf für Kunststoffe aus dem Automobilbau: Abfälle aus technischen Kunststoffen werden zu Pyrolyseöl verarbeitet, das für neue Bauteile eingesetzt werden kann |
| 103 | 19.11.2020 | ![]() |
Auch Alltagsaktivitäten steigern das Wohlbefinden Neurobiologische Mechanismen untersucht: Neue Erkenntnisse zum Zusammenhang von körperlicher Aktivität und Wohlbefinden im Alltag – Veröffentlichung in Science Advances |
| 102 | 18.11.2020 | ![]() |
RABus bringt selbstfahrende Busse auf die Straße Neues Verbundprojekt testet elektrifizierte und automatisierte Fahrzeuge im regulären Verkehr – KIT erforscht Akzeptanz und Wirkungen |
| 101 | 13.11.2020 | ![]() |
KIT wird Zentrum für Nationales Hochleistungsrechnen Millionenförderung für künftige Supercomputer am KIT – Forschende in ganz Deutschland können enorme Karlsruher Rechenleistung nutzen |
| 100 | 12.11.2020 | ![]() |
Aerobuster jagt herumfliegende Corona-Viren Forschende des KIT bauen preiswerten und leistungsstarken Apparat, der Krankheitserreger aus der Raumluft holen und inaktivieren kann |
| 099 | 10.11.2020 | ![]() |
Green Deal: Gut für ein klimaneutrales Europa – schlechter für den Planeten Import von Millionen Tonnen Getreide und Fleisch pro Jahr untergräbt landwirtschaftliche Standards der EU – Umweltschäden werden so aus der EU ausgelagert |
| 098 | 05.11.2020 | ![]() |
Enorme Beschleunigung für die Medikamentenforschung Prozesse können 10 000-mal schneller ablaufen – Europäischer Forschungsrat fördert Forscher des KIT und Partner im Projekt HiSCORE |
| 097 | 05.11.2020 | ![]() |
Vortragsreihe: Kulturwissenschaft gestern und morgen „Das vom Menschen Gemachte“: Colloquium Fundamentale am KIT widmet sich im Wintersemester der Disziplin zur Erforschung der Kultur |
| 096 | 23.10.2020 | ![]() |
Blutgefäße gezielt und schnell vergrößern Nature Communications: Forschende des KIT stimulieren gezielte Vergrößerung von Endothelzellen in Arteriolen – Grundlagen für eine bessere Behandlung von Herzinfarkten und Schlaganfällen |
| 095 | 20.10.2020 | ![]() |
KI übertrifft Mensch bei Spracherkennung Forscherinnen und Forscher am KIT haben weltweit erstes Spracherkennungssystem entwickelt, das besser arbeitet als der Mensch und schneller ist als andere KIs |
| 094 | 16.10.2020 | ![]() |
Künstliche Intelligenz zum Schutz des Grundwassers BMU bewilligt KI-Leuchtturmprojekt „Nitrat-Monitoring 4.0“ für die Reduzierung von Nitrat im Grundwasser |
| 093 | 15.10.2020 | ![]() |
Langfristig Zugriff auf Forschungsdaten sichern Eröffnung der Geschäftsstelle der Nationalen Forschungsdateninfrastruktur (NFDI) in Karlsruhe |
| 092 | 15.10.2020 | ![]() |
Jung bleiben im Alter mit Assistenzrobotern KIT entwickelt neue Generation von vielseitigen und personalisierbaren humanoiden Robotern für Senioren – Carl-Zeiss-Stiftung fördert Projekt mit 4,5 Millionen Euro |
| 091 | 14.10.2020 | ![]() |
Mobilität in der Stadt: Miteinander oder in der Quere In dem neuen Verbundprojekt „Cape Reviso“ ermitteln Forschende des KIT, wie Radfahrer und Fußgänger sich fühlen, wenn sie im Verkehr aufeinandertreffen |
| 090 | 12.10.2020 | Corona-Antikörper: Hohe Testbereitschaft, wenn Kosten niedrig sind Zu hohe Kosten und Aufwand mindern die Testbereitschaft – Forscherinnen des KIT und der University of California San Diego (UCSD) plädieren deshalb für einen einfachen Zugang zum Test |
|
| 089 | 08.10.2020 | ![]() |
Globale Nahrungsmittelproduktion bedroht das Klima Einsatz von Stickstoffdüngern in der Landwirtschaft lässt Lachgaskonzentration in der Atmosphäre stark steigen – Umfassende Studie unter Beteiligung des KIT in Nature |
| 088 | 08.10.2020 | ![]() |
Artenverlust betrifft Lebensgrundlagen des Menschen Jena Experiment: Biodiversität entscheidet über Funktionieren von Ökosystemen – Ergebnisse in Nature Ecology & Evolution |
| 087 | 06.10.2020 | ![]() |
Saisonale Prognosen verbessern die Lebensmittelversorgung EU-Projekt CONFER gestartet – Niederschlagsvorhersagen verringern die Auswirkungen von Dürren und Überschwemmungen in Ostafrika |
| 086 | 05.10.2020 | ![]() |
Sportwissenschaft: Qualität gewinnt Spiele Forschende des KIT analysieren Erfolgsfaktoren im Fußball – Zum Sieg führen vor allem eine gute Defensive, präzise und effiziente Spielaktionen sowie teure Spieler |
| 085 | 01.10.2020 | ![]() |
U-SARAH live will Staus und Schadstoffemissionen im Straßenverkehr reduzieren Projekt des Bundesverkehrsministeriums zur Optimierung von Streckenbeeinflussungsanlagen auf Autobahnen gestartet |
| 084 | 30.09.2020 | ![]() |
Energie System 2050: Lösungen für die Energiewende Die Forschungsinitiative der Helmholtz-Gemeinschaft präsentiert Strategien, Technologien und Open-Source-Werkzeuge |
| 083 | 29.09.2020 | KI für Ingenieure beherrschbar machen Verlässliche und sichere KI-Systeme für Ingenieure fehlen – Karlsruher Kompetenzzentrum bietet Hilfestellung für Unternehmen |
|
| 082 | 28.09.2020 | ![]() |
Neuer Forschungspodcast „Selbstbewusste KI“ Expertinnen und Experten diskutieren Fragen rund um das Bewusstsein von Künstlicher Intelligenz |
| 081 | 24.09.2020 | ![]() |
Streckbank für Zellen Eine raffinierte, wenige Mikrometer kleine Vorrichtung macht es möglich, die Reaktion einzelner biologischer Zellen auf mechanischen Stress zu untersuchen – Publikation in Science Advances |
| 080 | 23.09.2020 | ![]() |
Entwicklung ultra-kompakter Radarsensoren für Unternehmen DFG und FhG fördern Projekt zum Transfer von wissenschaftlichen Erkenntnissen des KIT in die Wirtschaft |
| 079 | 22.09.2020 | ![]() |
Edelmetallcluster können Katalysatoren leistungsfähig machen und Ressourcen schonen Optimierte Verteilung von Atomen erlaubt kostengünstigere Produktion – Publikation in Nature Catalysis |
| 078 | 15.09.2020 | ![]() |
Geringere CO₂-Emissionen durch Corona-Beschränkungen noch nicht in der Atmosphäre erkennbar Auswirkungen der Pandemie zeigen sich in der Atmosphäre erst spät – Zum Erreichen der Pariser Klimaziele sind jahrzehntelange Maßnahmen erforderlich |
| 077 | 09.09.2020 | ![]() |
Neuartiger Fotolack ermöglicht 3D-Druck kleinster poröser Strukturen Forschende des Exzellenzclusters 3D Matter Made to Order erweitern die Möglichkeiten des Zwei-Photonen-Mikrodrucks |
| 076 | 08.09.2020 | ![]() |
Terahertz-Empfänger für 6G-Mobilfunknetze Am KIT entwickeltes Konzept ermöglicht hohe Datenübertragungsraten bei niedrigen Kosten – bislang höchste Datenrate in der Terahertz-Kommunikation – Publikation in Nature Photonics |
| 075 | 04.09.2020 | ![]() |
Vererbung bei Pflanzen lässt sich nun gezielt steuern Forschende am KIT verändern mit der molekularen Schere CRISPR/Cas erstmals Abfolge der Gene innerhalb eines Chromosoms – Nature Communications veröffentlicht Ergebnisse |
| 074 | 03.09.2020 | ![]() |
DNA-Schäden durch wandernde Lichtenergie UV-Strahlung verändert DNA auch sehr weit entfernt von der Eintrittsstelle des Lichts – Veröffentlichung in der Fachzeitschrift Angewandte Chemie |
| 073 | 02.09.2020 | ![]() |
Elektroden schneller trocknen – Batterien kostengünstiger herstellen Projekt EPIC zielt auf energetische, ökonomische und ökologische Optimierung der Produktion |
| 072 | 31.08.2020 | ![]() |
Neues Verfahren: Steroidhormone effizient aus Wasser entfernen Verbessertes Filtrationssystem aus Polymermembran mit aktiviertem Kohlenstoff eliminiert Östradiol zu mehr als 99 Prozent – Forschende des KIT berichten in Water Research |
| 071 | 19.08.2020 | ![]() |
Schroff Kolleg: Neues Wohnheim für Studierende des KIT Mit Unterstützung der Schroff Stiftungen entsteht in der Hagsfelder Allee zusätzlicher Wohnraum mit Platz für 103 Studierende |
| 070 | 17.08.2020 | ![]() |
Flexibles Produktionssystem für Variantenvielfalt Ingenieure des KIT und Industriepartner arbeiten an der wirtschaftlichen Fertigung von individualisierten Industrie- und Konsumgütern |
| 069 | 13.08.2020 | ![]() |
Klimawandel: Mischwälder sind anpassungsfähiger als Monokulturen Wissenschaftlerinnen und Wissenschaftler des KIT und der Universität Freiburg untersuchen den Umbau von Rein- in Mischbestände – Buchen-Tannen-Mischungen mit hohem Potenzial |
| 068 | 12.08.2020 | ![]() |
Rohstoffe für Energie- und Mobilitätstechnologien Geologen untersuchen im Oberrheingraben Prozesse der Metallanreicherung in Geothermalwässern – DFG-Projekt erforscht potenzielle Wertstoffe in Tiefenwässern |
| 067 | 11.08.2020 | ![]() |
Effiziente Gastrennung dank poröser Flüssigkeiten Neues Material eröffnet die Möglichkeit, beim Abtrennen von Rohstoffen für die Kunststoffindustrie bis zu 80 Prozent Energie einzusparen – Publikation in Nature Materials |
| 066 | 29.07.2020 | ![]() |
Mobilität 2035: Technologiekalender unterstützt kleine und mittlere Unternehmen beim Wandel Studie vergleicht Mobilitätsszenarien und hilft bei strategischen Entscheidungen |
| 065 | 28.07.2020 | EPICUR: EU-Kommission fördert auch Forschung KIT koordiniert „EPICUR Research“ – Aufgaben der Partner umfassen neben Studierendenmobilität und Innovation auch Forschungsaktivitäten und den Dialog mit der Gesellschaft |
|
| 064 | 28.07.2020 | ![]() |
Anodenmaterial für sichere und langlebige Batterien Lithium-Lanthan-Titanat-Partikel ermöglichen selbst in Mikrometergröße hohe Leistungsdichten – Publikation in Nature Communications |
| 063 | 22.07.2020 | ![]() |
Erste bundesweite Regenmessung mit dem Mobilfunknetz Niederschlagsbedingte Abschwächung der Funkverbindung ermöglicht zeitlich hoch aufgelöste Regenkarten |
| 062 | 21.07.2020 | ![]() |
Open Source für die globale Energiewende Zugangsfreie, offene Software, Benchmarks und Datensätze: Energy Computing Initiative der Helmholtz-Gemeinschaft unterstützt die klimafreundliche Transformation von Energiesystemen |
| 061 | 17.07.2020 | ![]() |
Neues EU-Projekt soll Batterieentwicklung beschleunigen In der europäischen Initiative BATTERY 2030+ startet eine neuartige Batterieentwicklungsstrategie – Forschungsplattform CELEST mit KIT und Universität Ulm beteiligt |
| 060 | 14.07.2020 | ![]() |
Aerosole beeinflussen Solarstromertrag in Europa Forschungsprojekt von KIT, dem Deutschen Wetterdienst und meteocontrol untersucht, wie winzige Schwebeteilchen in der Luft das Wetter und die Sonneneinstrahlung verändern |
| 059 | 13.07.2020 | ![]() |
Verbesserte Prüfverfahren für sichere Batteriesysteme Zwischen Worst Case und Realität: Das KIT arbeitet gemeinsam mit Partnern an neuen Prüfverfahren und Normen für Lithium-Ionen-Zellen in Batteriesystemen |
| 058 | 09.07.2020 | ![]() |
KIT forscht in vier neuen Batterie-Kompetenzclustern Verbünde zu Agiler Produktion, Recycling, Nutzungskonzepte und Qualitätssicherung – BMBF fördert mit insgesamt 100 Millionen Euro |
| 057 | 08.07.2020 | ![]() |
Fahrerkabine 4.0: Automatisiertes Belastungsmanagement Agrarsysteme der Zukunft: Forscherinnen und Forscher des KIT entwickeln anpassungsfähige Mensch-Maschine-Schnittstelle für Mähdrescher |
| 056 | 06.07.2020 | ![]() |
Superschnelles KI-System am KIT installiert Eines der leistungsstärksten KI-Computersysteme in Europa unterstützt ab sofort Wissenschaftlerinnen und Wissenschaftler bei der Lösung von Menschheitsproblemen |
| 055 | 02.07.2020 | ![]() |
Maßgeschneiderte Katalysatoren für Power-to-X Mit einem Synchrotron schauen Wissenschaftlerinnen und Wissenschaftler des KIT einem Power-to-X-Katalysator bei der Arbeit zu |
| 054 | 01.07.2020 | ![]() |
Neues Verfahren ermöglicht Lithiumabbau in Deutschland Wissenschaftlerinnen und Wissenschaftler des KIT patentieren minimalinvasive Technologie zur Gewinnung von Lithium in Geothermieanlagen |
| 053 | 30.06.2020 | ![]() |
Erdbebenforschung: Immense Datenmengen mit Künstlicher Intelligenz auswerten Geophysik: Land unterstützt KI-Projekt KISS in „Kleinen Fächern“ – Helmholtz fördert Projekt REPORT-DL |
| 052 | 26.06.2020 | ![]() |
Nationale Forschungsdateninfrastruktur: Drei Konsortien mit Beteiligung des KIT gefördert Chemie, Ingenieurwissenschaften und Katalyseforschung in erster Ausschreibungsrunde erfolgreich |
| 051 | 25.06.2020 | ![]() |
Neuer Kandidat für Rohstoffsynthese durch Gentransfer „Natürlicher Gentransfer“ in mehrzelliges Cyanobakterium: Phormidium lacuna lässt sich für Grundlagenforschung und biotechnische Anwendungen nutzen |
| 050 | 22.06.2020 | ![]() |
COVID-READY hilft Hotels in und nach der Pandemie Ausgründung aus dem KIT bietet Software und Zertifizierung für Hygiene- und Schutzmaßnahmen |
| 049 | 12.06.2020 | ![]() |
Maximal 20 pro Jahr: Ein klares Ziel für den Artenschutz Wissenschaftlerinnen und Wissenschaftler fordern mit Grenzwert für die Zahl ausgestorbener Spezies ähnlichen Grundsatz wie das Zwei-Grad-Ziel für den Klimaschutz |
| 048 | 09.06.2020 | ![]() |
Phishing-Kampagnen und ihre Fallstricke Forscherinnen des Karlsruher Instituts für Technologie und der Ruhr-Universität Bochum analysieren die Wirkung vorgetäuschter Phishing-Mails zur Sensibilisierung von Angestellten |
| 047 | 08.06.2020 | ![]() |
KI unterstützt Fachkräfte bei der Montage Kimoknow, eine Ausgründung des KIT, entwickelt digitalen Montageassistenten – Basis ist die automatisierte KI-gestützte Objekterkennung |
| 046 | 05.06.2020 | ![]() |
Neue Quantenmaterialien mit einzigartigen Merkmalen KIT ist an Sonderforschungsbereich/Transregio ELASTO-Q-MAT beteiligt – Wechselwirkungen zwischen mechanischen und elektronischen Eigenschaften bergen großes Anwendungspotenzial |
| 045 | 04.06.2020 | ![]() |
Besser gerüstet gegen Waldbrände Institutsübergreifendes Projekt trägt dazu bei, die Dynamik von Waldbränden zu verstehen und das Risiko zu senken |
| 044 | 03.06.2020 | ![]() |
Kavli-Preis für Wegbereiter der Elektronenmikroskopie Maximilian Haider, Harald Rose, Knut Urban und Ondrej Krivanek werden für ihre Beiträge zur Entwicklung der Elektronenmikroskopie mit dem Kavli-Preis 2020 ausgezeichnet |
| 043 | 02.06.2020 | ![]() |
Coronavirus: Reproduktionszahl genauer geschätzt Forscher des KIT entwickeln neue Methode mit akausalem Sieben-Tage-Filter zur Bestimmung des R-Werts bei Infektionskrankheiten |
| 042 | 29.05.2020 | Datenschutz beim Website-Tracking Informatiker des KIT und der TU Dresden untersuchen, wie gut das Generalisieren von Trackingdaten unsere Spuren im Internet verwischt |
|
| 041 | 28.05.2020 | ![]() |
Am KIT finden wieder schriftliche Klausuren statt Kooperation mit der Messe Karlsruhe ermöglicht es auch großen Gruppen von Studierenden, verschobene Präsenzprüfungen nachzuholen |
| 040 | 27.05.2020 | ![]() |
Lebensmitteltechnik: Mehle auf Insektenbasis Forscherinnen und Forscher verbessern die Backeigenschaften von Insektenmehlen |
| 039 | 26.05.2020 | ![]() |
Mit KI in der Landwirtschaft Wasser sparen Das Start-up heliopas.ai aus dem KIT hilft Landwirten mit der Smartphone-App „Waterfox“, ihre Felder effizienter zu bewässern – Neue Folge der interaktiven Videoreihe „Sachen machen mit KI“ |
| 038 | 25.05.2020 | ![]() |
Arme zwischen Chromosomen mit molekularer Schere ausgetauscht CRISPR/Cas revolutioniert Pflanzenzüchtung über gezieltes Kombinieren von Eigenschaften – Neue Technik zur Genomveränderung im Magazin Nature Plants vorgestellt |
| 037 | 20.05.2020 | ![]() |
Neue Lösungen für textile Biogasspeichersysteme Forscherinnen und Forscher des KIT haben mit einer Testanlage untersucht, wie sich textile Speicher für Biogas verbessern lassen |
| 036 | 19.05.2020 | ![]() |
Wie effizient arbeiten Photovoltaik-Speichersysteme? Projekt „Testbench“ verbessert Qualität der Messergebnisse und erleichtert den Vergleich |
| 035 | 14.05.2020 | ![]() |
Neuer Supercomputer für das KIT Hybridsystem „HoreKa“ voraussichtlich einer der zehn schnellsten Rechner in Europa in 2021 |
| 034 | 14.05.2020 | ![]() |
Nachhaltige Produktion: Neuer Forschungsschwerpunkt am KIT Kreislaufwirtschaftssystem in Produktionsprozessen ermöglichen |
| 033 | 13.05.2020 | ![]() |
Mikrobielle Cyborgs: Bakterien als Stromlieferanten Wissenschaftlerinnen und Wissenschaftler des KIT entwickeln programmierbares, biohybrides Materialsystem, das Bakterien zur Erzeugung von Strom nutzt |
| 032 | 12.05.2020 | ![]() |
Neue Moleküle für innovative Hightech-Materialien Deutsche Forschungsgemeinschaft fördert Arbeit an Sandwich-Komplexen von Professor Peter Roesky über ein Reinhart Koselleck-Projekt |
| 031 | 07.05.2020 | ![]() |
Datenschutzfreundliche Corona-Tracing-App Forscher des KIT und des FZI entwickeln Kompromissvorschlag aus zentraler und dezentraler Lösung für eine höhere Privatsphäre |
| 030 | 04.05.2020 | ![]() |
Agiles Produktionssystem für Elektromotoren Baden-württembergisches Wirtschaftsministerium fördert Forschungsprojekt am KIT mit rund einer Million Euro |
| 029 | 29.04.2020 | ![]() |
Live-Stream: Colloquium Fundamentale zur Bioökonomie Öffentliche Vortragsreihe „Fossile Rohstoffe ade! Forschung auf dem Weg in die Bioökonomie“ widmet sich den Herausforderungen einer nachhaltigen, biobasierten Wirtschaftsweise |
| 028 | 15.04.2020 | ![]() |
Duftstoff der Minze hemmt Wachstum von Unkräutern Neuer Ansatz für nachhaltige Unkrautbekämpfung untersucht biologische Kommunikation zwischen Pflanzen – Menthon hat Potenzial als Bioherbizid |
| 027 | 14.04.2020 | ![]() |
KIT unterstützt Karlsruher Kliniken mit Schutzausrüstung Corona-Hilfe: Masken und Visiere gehen unter anderem an Städtisches Klinikum und ViDia Kliniken – zentrale Koordination von Hilfsanfragen und -angeboten am KIT |
| 026 | 14.04.2020 | ![]() |
Auf der Suche nach dem Z‘-Boson Wissenschaftler des KIT sind an Beschleuniger-Experiment Belle II beteiligt, das nun erste Ergebnisse veröffentlicht hat |
| 025 | 09.04.2020 | ![]() |
Roadmap für die Batterieforschung in Europa Die europäische Forschungsinitiative BATTERY 2030+ präsentiert ihre Ziele – Forschungsplattform CELEST mit KIT, Universität Ulm und ZSW beteiligt |
| 024 | 08.04.2020 | ![]() |
Ortungssystem für in Not geratene Rettungskräfte Sicherheit auf Schritt und Tritt: Forschende des KIT entwickeln Technologie, um verletzte oder verschüttete Einsatzkräfte – ohne GPS – zu lokalisieren |
| 023 | 07.04.2020 | ![]() |
Sommersemester am KIT startet online Studienbetrieb läuft mit rein digitalen Angeboten am 20. April 2020 an |
| 022 | 31.03.2020 | ![]() |
Skalierbare Algorithmen für viele Anwendungen Europäischer Forschungsrat fördert Projekt „ScAlBox“ von Peter Sanders mit Advanced Grant |
| 021 | 30.03.2020 | ![]() |
Arbeiten in der Zeit der Pandemie Eine kompakte Handreichung zum verteilten Arbeiten hilft Unternehmen, die ihre Mitarbeiterinnen und Mitarbeiter ins Homeoffice schicken müssen |
| 020 | 30.03.2020 | ![]() |
Neue Materialien: Strahlendes Weiß ohne Pigmente Nanostrukturierte Polymerfolie erreicht weiße Optik ohne Einsatz von umweltbelastendem Titandioxid – Käferpanzer als Vorbild |
| 019 | 25.03.2020 | ![]() |
Vom Treibhausgas zum Hightech-Rohstoff Technologien für negative Treibhausgasemissionen: Im Forschungsprojekt NECOC entsteht am KIT eine Versuchsanlage zur Umwandlung von CO2 aus der Umgebungsluft in festen Kohlenstoff |
| 018 | 17.03.2020 | ![]() |
Pflanzenschutz: Kommunikation statt Giftkeule Nachhaltig: Vom KIT koordiniertes transnationales Netzwerk erforscht chemische Signale zwischen Krankheitserreger und Pflanze – EU fördert mit 500.000 Euro |
| 017 | 05.03.2020 | ![]() |
Bei extremer Hitze und Trockenheit profitieren Bäume kaum von erhöhtem CO2 Untersuchungen an Aleppo-Kiefern zeigen: Anstieg der Kohlendioxid (CO2)-Konzentration in der Atmosphäre gleicht die negative Wirkung des Klimawandels nicht aus |
| 016 | 02.03.2020 | ![]() |
Informatiker York Sure-Vetter vom KIT wird Direktor der Nationalen Forschungsdateninfrastruktur (NFDI) FIZ Karlsruhe und KIT haben Aufgaben des Gründungsdirektorats übernommen |
| 015 | 24.02.2020 | ![]() |
Datenbasiert zu optimierten Energiesystemen Start-up greenventory bietet Daten und Software für Versorger und Netzbetreiber, Städte und Quartiere |
| 014 | 19.02.2020 | ![]() |
Haben ein Auge für Farben: druckbare Lichtsensoren Team des KIT entwickelt druckbare organische Fotodioden, die Wellenlängen unterscheiden und damit Datenübertragung via Licht ermöglichen können. |
| 013 | 17.02.2020 | ![]() |
Hasso Plattner erhält Ehrendoktorwürde Der Unternehmer, Stifter und Mäzen besuchte zur feierlichen Übergabe der Urkunde am KIT seine Alma Mater. |
| 012 | 17.02.2020 | ![]() |
AgiloBat: Batteriezellen flexibel produzieren Im Forschungsprojekt AgiloBat arbeiten KIT und Partner an der Zukunft der Batteriefertigung in Deutschland |
| 011 | 11.02.2020 | ![]() |
Innovative Power-to-Gas-Technologien für die Energiewende Abschlusskonferenz zum EU-Forschungsprojekt STORE&GO am KIT |
| 010 | 03.02.2020 | ![]() |
Dorothea Wagner Vorsitzende des Wissenschaftsrats Informatikerin des KIT als dritte Frau an die Spitze von Deutschlands wichtigstem forschungspolitischem Beratungsgremium gewählt |
| 009 | 03.02.2020 | ![]() |
Mit Künstlicher Intelligenz Werkzeugmaschinen warten Verschleiß an der Spindel in Kugelgewindetrieben kann mit einem intelligenten System aus dem KIT kontinuierlich überwacht und bewertet werden |
| 008 | 30.01.2020 | ![]() |
Exzessives Sporttreiben bei Essstörungen: psychologische Mechanismen entschlüsselt Ergebnisse liefern wichtige Implikationen für Prävention und Therapie – Veröffentlichung in Psychotherapy and Psychosomatics |
| 007 | 28.01.2020 | ![]() |
Schnellster hochpräziser 3D-Drucker Wissenschaftlerinnen und Wissenschaftler des KIT entwickeln neues 3D-Drucksystem für submikrometergenaue Strukturen in Rekordgeschwindigkeit – Publikation in Advanced Functional Materials |
| 006 | 27.01.2020 | ![]() |
Girls' Day 2020: Studium und Ausbildung am KIT Informationstag für Schülerinnen ab der fünften Klasse mit Workshops, Führungen und Vorträgen – Anmeldung jetzt möglich! |
| 005 | 22.01.2020 | ![]() |
Neue Veranstaltungsreihe: ENERGIE – Wende. Wandel. Wissen. Wissenschaftlerinnen und Wissenschaftler des KIT diskutieren mit interessierten Bürgerinnen und Bürgern über Energieforschung und Energiewende |
| 004 | 21.01.2020 | ![]() |
KIT im Rathaus: Städte und Wetterextreme Bei der Veranstaltung stellt sich das KIT-Zentrum Klima und Umwelt mit seiner Forschung vor |
| 003 | 16.01.2020 | ![]() |
Ein bisschen gut ist gut genug – Ausreden und Ablasseffekte beim Konsum Studie des KIT zeigt, dass bereits eine einzelne ethische Verbesserung ausreicht, um weitere Aspekte beim Kauf nicht mehr zu beachten und unmoralisches Verhalten zu rechtfertigen. |
| 002 | 13.01.2020 | Zumeldung zur Forderung von Ministerpräsident Kretschmann nach stärkeren Kooperationen der Hochschulen in Baden-Württemberg Hanselka: Kompetenzen bündeln – sehr gute strategische Partnerschaften am KIT |
|
| 001 | 13.01.2020 | ![]() |
Mit Produktionstechnik zur nachhaltigen Mobilität Im Innovationscampus „Mobilität der Zukunft“ bereiten KIT und Universität Stuttgart Ideen und Geschäftsmodelle für die nachhaltige Mobilität von übermorgen vor |